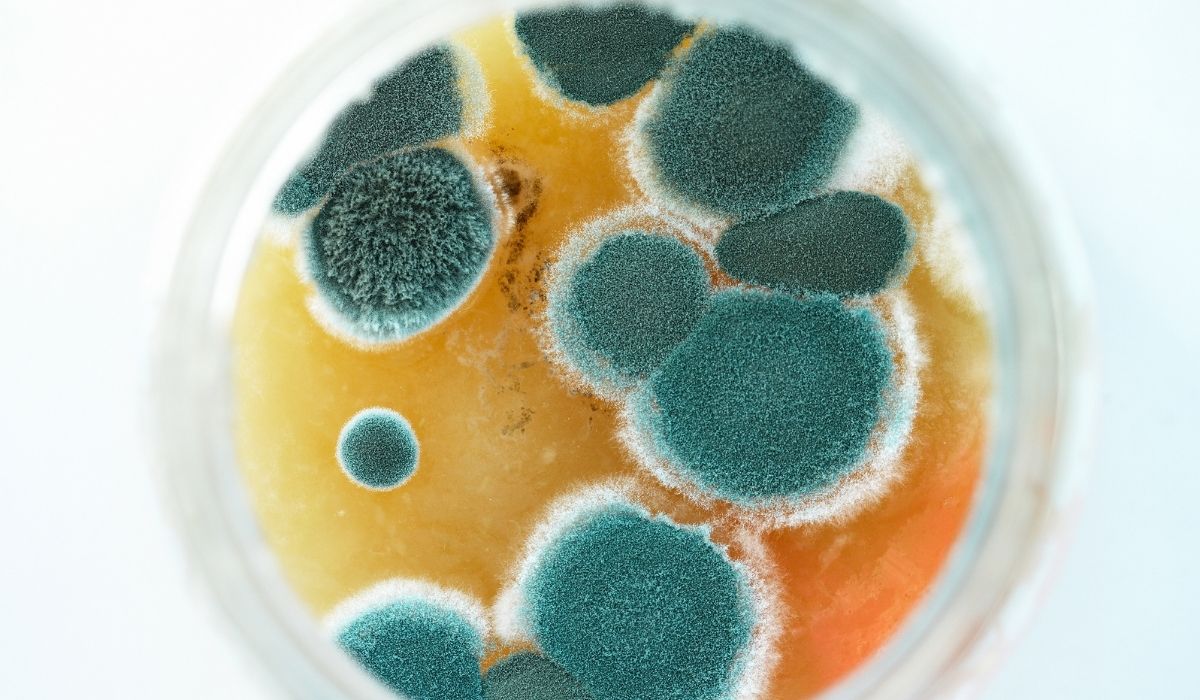
mold contaminated

How to test your house for mold?
Mold is a type of fungus that grows in damp places. It can show up after water damage, leaks, floods, or even high humidity. Some mold is easy to see, but a lot of mold can hide behind walls, under floors, or inside vents.
If you smell a musty odor, see stains, or feel sick at home, you may wonder: How do I test my house for mold? This guide walks you through safe, simple steps—plus when to call a certified mold inspector or a water damage restoration team.
Why Testing for Mold Matters After Water Damage
Mold can start growing when materials stay wet for too long. A small leak under a sink or a damp carpet can turn into a bigger problem if it’s ignored.
Testing matters because it helps you:
- Find hidden mold
- Confirm if spots are mold or just dirt
- Understand if mold may be in the air
- Decide if you need mold remediation (professional cleanup)
If your home had a recent leak, overflow, roof damage, or flooding, mold testing is a smart next step—especially to support your water damage restoration plan.
Common Signs You Might Have Mold
Before you buy a mold test kit, do a quick check. Mold problems often leave clues.
Visual signs
- Black, green, white, or brown spots on walls or ceilings
- Bubbling paint or peeling wallpaper
- Warped baseboards or swollen drywall
- Water stains that keep coming back
Smell and air clues
- A strong musty smell (like wet socks or old paper)
- Rooms that feel damp even with the AC running
- Odors that get worse when doors stay closed
Health clues (some people are more sensitive)
- Sneezing, itchy eyes, or coughing at home
- Worsening asthma symptoms
- Headaches or stuffy nose indoors
If you see mold growth, you may not need a test to “prove” it’s there. But testing can help you learn where it’s coming from and how far it may have spread.

Safety First Before You Test
Mold spores are tiny. When you disturb mold, spores can spread.
Basic safety gear
- Gloves
- Safety glasses
- An N95 mask (or better)
- A trash bag for used supplies
Important safety tips
- Don’t scrub large areas of suspected mold
- Don’t open walls unless you know what you’re doing
- Keep kids and pets away from the area
- If the moldy area is large, stop and call a pro
A common guideline is: if mold covers a big area (like more than a small patch), or if you have a lot of water damage, professional help is safer.
Step 1: Do a Full Home Mold Inspection With Your Eyes and Nose
A “mold test” starts with a good inspection. Walk through your home slowly and check problem areas.
Where to look first
- Bathrooms (around tubs, toilets, sinks)
- Kitchens (under sinks, behind the fridge, dishwasher)
- Laundry rooms (behind washers, near vents)
- Basements and crawl spaces
- Attics (roof leaks, wet insulation)
- Windows and sliding doors (condensation)
- HVAC vents and air returns
What to look for
- Dark spotting or fuzzy growth
- Damp drywall or soft wood
- Condensation on pipes
- Rust on metal vents (can mean moisture)
If you can, take photos and write down where you find stains, smells, or moisture. This helps if you decide to hire a mold inspection company later.
Step 2: Check Moisture Levels (Because Mold Needs Water)
Mold almost always means there is a moisture problem.
Easy moisture checks
- Touch surfaces: do they feel damp or cool?
- Look for active leaks: dripping pipes, wet cabinets
- Check humidity: ideal indoor humidity is often around 30%–50%
- Notice condensation: windows sweating can mean excess moisture
Helpful tools
- Moisture meter: checks dampness inside drywall, wood, and floors
- Hygrometer: measures humidity in the air
- Infrared (IR) camera: pros use this to find hidden water behind walls
If you find high moisture, fix the water source fast. Mold testing helps, but stopping moisture is what prevents mold from coming right back.
Step 3: Choose the Right Type of Mold Test
There isn’t just one “best” mold test. The right choice depends on your goal.
Surface sampling (swab/tape test)
Best for: testing a suspicious spot on a wall, ceiling, or baseboard
How it works: you swab the area or press tape, then send it to a lab (or use a kit)
Air sampling (air test)
Best for: checking if mold spores may be floating in the air
How it works: a pump pulls air through a cassette that gets tested in a lab
Note: air tests work best when done by trained pros who compare indoor vs. outdoor air.
Petri dish “settle plate” kits
Best for: basic awareness, not detailed proof
How it works: you open a dish and see what grows
Important: many things grow in petri dishes, not only harmful mold. This can confuse homeowners.
If you want clear, useful results, lab-tested kits or professional sampling are usually better than “grow-it-yourself” plates.
Step 4: How to Use a DIY Mold Test Kit (Without Messing It Up)
DIY mold test kits can help in small situations. They’re most useful when you:
- Have a small spot you want identified
- Want lab results to understand the type of mold
- Need documentation before repairs (in some cases)
Tips for better results
- Read instructions fully before opening anything
- Turn off fans and HVAC for a short time if the kit says so
- Don’t test right after cleaning with bleach or strong chemicals
- Label every sample (room, location, date, time)
- Avoid touching the sampling surface with your fingers
Common DIY mistakes
- Testing the wrong spot (missing the real source)
- Taking a sample from a dirty area and assuming it’s mold
- Using only one test when multiple rooms smell musty
- Ignoring moisture (the root cause)
A test result is only part of the story. If the home is wet, mold can return even after cleaning.
Step 5: When You Should Hire a Professional Mold Inspector
Sometimes DIY testing isn’t enough—especially after major water damage.
You should consider a pro if:
- You had flooding, sewage backup, or a big leak
- You see repeated stains that keep coming back
- You smell mold but can’t find it (hidden mold)
- Someone in the home has asthma, allergies, or breathing issues
- You’re buying or selling a home and need clear documentation
- The moldy area is large or spread across rooms
A professional may use:
- Moisture meters and thermal imaging
- Air sampling pumps
- Wall cavity checks
- HVAC inspection
- Lab analysis for common molds like Cladosporium, Aspergillus, Penicillium, and sometimes Stachybotrys chartarum (often called “black mold”)
A qualified inspector can also explain what the results mean and what to do next.
What Mold Test Results Can (and Can’t) Tell You
What results can tell you
- If mold is present in a sample
- The general type (genus) and amount found in a lab result
- If indoor air may have higher spore levels than expected
What results can’t always tell you
- Exactly where all mold is hiding
- How harmful it is for every person
- Whether you can “clean it and forget it” without fixing moisture
Think of mold testing like a smoke alarm. It tells you there’s a problem—but you still have to find the source and fix it.
What to Do If You Find Mold in Your Home
If your test or inspection points to mold, focus on two goals: stop the water and remove the damaged materials safely.
Quick first steps
- Fix leaks (roof, plumbing, appliances)
- Dry wet areas fast (fans + dehumidifier)
- Keep humidity under control
- Don’t paint over stains (mold can keep growing underneath)
When you may need mold remediation
- Mold is in drywall, insulation, or behind cabinets
- The smell is strong and won’t go away
- The water damage happened days ago and materials stayed wet
- You see mold in HVAC vents or returns
A professional water damage restoration team can dry your home correctly and prevent mold from spreading during repairs. If you’re creating this content to support your water damage restoration pillar page, it’s worth stressing this: drying the structure quickly and correctly is one of the best ways to prevent long-term mold problems.
How to Prevent Mold After Testing
Testing helps you find mold. Prevention helps you keep it from coming back.
Mold prevention checklist
- Use bathroom fans during and after showers
- Run a dehumidifier in damp areas (basements, laundry rooms)
- Repair leaks fast (same day if possible)
- Keep gutters clean and water draining away from the home
- Check under sinks monthly
- Insulate cold pipes to reduce condensation
- Keep HVAC filters clean and replace as recommended
Stopping moisture is the real “mold prevention plan.”

FAQs
Can I test for mold myself without a professional?
Yes. You can do a visual inspection, check humidity, and use a DIY mold test kit (surface or sometimes air). DIY tests work best for small concerns. If you have hidden mold or major water damage, a professional inspection is usually more accurate.
What is the most accurate mold test for a house?
Professional testing is often the most accurate because inspectors use moisture tools, proper air sampling pumps, and lab analysis with indoor/outdoor comparisons. Lab-based surface samples can also be accurate for identifying a suspicious spot.
Are petri dish mold test kits reliable?
They can show that “something” in the air can grow, but they don’t always tell you what it is or where it came from. Many normal spores can grow in a dish, so results can be confusing without lab testing.
How do I know if mold is behind a wall?
Common signs include a musty smell you can’t find, bubbling paint, soft drywall, warping, or stains that return. A moisture meter and thermal imaging (often used by pros) can help locate hidden wet areas behind walls.
If I find mold, should I clean it or call a restoration company?
Small surface spots may be cleaned carefully, but if the area is large, keeps coming back, is caused by water damage, or may be in walls/HVAC, it’s safer to call a water damage restoration and mold remediation team. They can dry the structure and remove contaminated materials correctly.


